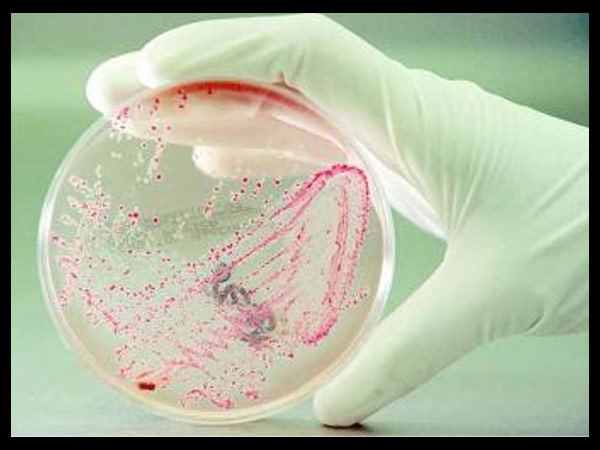
ഭയക്കണം രോഗാണുക്കളെ

നോട്ടെണ്ണുന്നവരാണോ എങ്കില് സൂക്ഷിക്കണം..... ഇന്ത്യന് കറന്സി പരത്തുന്നത് മാരക രോഗങ്ങള്?
ദില്ലി: പണം എണ്ണാത്തവരായി ലോകത്ത് ആരും തന്നെ ഉണ്ടാവില്ല. ഇന്ത്യയിലാണെങ്കില് നോട്ടുകള് എന്ന് പറയുന്നത് ആളുകളുടെ ദൈനം ദിന ജീവിതത്തിന്റെ ഭാഗമാണ്. ഡിജിറ്റല് ഇടപാടുകള് വലിയ രീതിയില് പുരോഗമിക്കാത്തത് കൊണ്ട് കറന്സികള് വാങ്ങുന്നതും കൊടുക്കുന്നതും ഇന്ത്യക്കാരില് കൂടുതലാണ്. എന്നാല് സ്വപ്നത്തില് പോലും കിട്ടാത്ത പണിയാണ് നോട്ടുകളില് നിന്ന് വരുന്നതെന്നാണ് മെഡിക്കല് വിദ്ഗ്ദര് പറയുന്നത്. നോട്ടുകള് വഴി മാരക രോഗങ്ങളാണ് പടരുന്നതെന്നാണ് റിപ്പോര്ട്ട്.
ചെറിയ രോഗങ്ങളല്ല വലിയ രോഗങ്ങളാണ് എല്ലാം. മരണം വരെ സംഭവിക്കാന് സാധ്യതയുള്ളതാണ് പലതും. എല്ലാവരെയും ഞെട്ടിക്കുന്ന റിപ്പോര്ട്ട് കൂടിയാണ്. നേരത്തെ തന്നെ ഈ കാര്യത്തില് അഭ്യൂഹങ്ങളുണ്ടെങ്കിലും കേന്ദ്ര സര്ക്കാര് ഒന്നും ചെയ്തില്ല. ഇത് അതിലേറെ ഞെട്ടിക്കുന്നതാണ്. അതേസമയം റിപ്പോര്ട്ടുകളെല്ലാം തട്ടിപ്പാണെന്നും നോട്ടില് നിന്ന് മാരക രോഗങ്ങളുണ്ടാവുന്നത് തമാശയാണെന്നും ബിജെപി പരിഹസിക്കുന്നു.

മാരക രോഗാണുക്കള്
പുതിയതും പഴയതുമായ നോട്ടുകള് ഒന്നും സുരക്ഷിതമല്ലെന്നാണ് അഖിലേന്ത്യാ വ്യാപാര സംഘടന പറയുന്നത്. പല പഠനങ്ങളും ഇന്ത്യയിലെ കറന്സികളില് മാരക രോഗാണുക്കള് ഉണ്ടെന്ന് കണ്ടെത്തിയിട്ടുണ്ടെന്ന് ഇവര് ആരോപിക്കുന്നു. അണ്ഡാശയ രോഗങ്ങള്, രക്തദൂഷ്യം, ശ്വാസകോശ സംബന്ധമായ രോഗങ്ങള്, വിഷബാധ കൊണ്ടുള്ള രോഗങ്ങള് തുടങ്ങിയവ വരാന് സാധ്യതയുണ്ടെന്ന് ഡോക്ടര്മാര് പറയുന്നു.

മൂല്യം കുറഞ്ഞ നോട്ടുകള്
മാരക രോഗം പരത്തുന്ന സൂക്ഷ്മാണുക്കള് നോട്ടുകളില് ഉണ്ടെന്നാണ് ഡോക്ടര്മാര് കണ്ടെത്തിയിരിക്കുന്നത്. ദക്ഷിണ ദില്ലിയിലെ മാര്ക്കറ്റുകളില് നിന്നാണ് ഡോക്ടര്മാര് ഇക്കാര്യം തിരിച്ചറിഞ്ഞത്. 10, 20 100 രൂപ നോട്ടുകളിലാണ് ഡോക്ടര്മാര് പരിശോധന നടത്തിയത്. ഇത് ആരോഗ്യ വകുപ്പിന്റെ ശ്രദ്ധയില്പ്പെടാതിരുന്നത് എന്തുകൊണ്ടാണെന്നും ഇവര് ചോദിക്കുന്നു.
ഭയക്കണം രോഗാണുക്കളെ
78 തരം മാരക രോഗങ്ങള് പരത്തുന്ന കീടാണുകളെയാണ് ഈ നോട്ടുകളില് കണ്ടെത്തിയതെന്ന് മെഡിക്കല് വിദഗ്ദ സംഘം പറഞ്ഞു. അതേസമയം ഓരോ നോട്ടിലും കുറഞ്ഞത് 78 തരം രോഗാണുക്കള് ഉണ്ടെന്നാണ് ഡോക്ടര്മാര് കണ്ടെത്തിയത്. ട്യൂബര്കുലോസിസിനും അള്സറിനും വരെ കാരണമാവുന്ന രോഗാണുക്കള് ഇക്കൂട്ടത്തിലുണ്ട്. ഇവയെ ഒരിക്കലും നോട്ടുകള് കൈമാറ്റം ചെയ്യുന്നവര്ക്ക് കണ്ണുകൊണ്ട് കാണാന് സാധിക്കില്ല.

വ്യാപാരികള്ക്ക് ഭയം
നോട്ടുകളുടെ നിരന്തരം ഇടപാട് നടത്തുന്ന ആളുകളെ രോഗം പെട്ടെന്ന് ബാധിക്കും. വ്യാപാരികളാണ് ഇതില് ഭയപ്പെടുന്നത്. അവര് നിരന്തരം നോട്ടുകള് വാങ്ങുകയോ കൈമാറുന്നവയോ ചെയ്യുന്നവരാണ്. അതേസമയം ഏതൊക്കെ തരം രോഗങ്ങള് വരാന് സാധ്യതയുണ്ടെന്ന കാര്യത്തില് കൂടുതല് പരിശോധന നടത്തുകയാണ് ഡോക്ടര്മാര്. എന്തായാലും എല്ലാവരും കരുതിയിരിക്കണമെന്ന നിര്ദേശമാണ് വിദഗ്ദര്ക്ക് നല്കാനുള്ളത്.

നാണയങ്ങളെയും ഭയക്കണം
നോട്ടുകളെ മാത്രമല്ല നാണയങ്ങളെയും ഭയക്കണമെന്നാണ് നിര്ദേശം. നാണയങ്ങളിലും സൂക്ഷമാണുക്കള് ഉണ്ട്. പക്ഷേ ഇത് വളരെ വൈകിയാണ് തിരിച്ചറിഞ്ഞത്. ഓട്ടോ റിക്ഷാ ഡ്രൈവര്മാര്, മെഡിക്കല് സ്റ്റോറുകള്, വ്യാപാരികള് എന്നിവരില് നിന്നുള്ള നാണയങ്ങള് വഴിയാണ് പ്രധാനമായും രോഗാണുക്കള് ജനവാസപ്രദേശങ്ങളിലേക്കെത്തുന്നത്. അതേസമയം ഇക്കാര്യം ആരോഗ്യ വകുപ്പ് ഇത് വരെ മനസ്സിലാക്കിയിട്ടില്ലെന്ന് വിമര്ശനമുണ്ട്. പ്രതിരോധ മാര്ഗങ്ങള് സ്വീകരിച്ചില്ലെങ്കില് മാരക രോഗങ്ങള് പടര്ന്നുപിടിക്കുമെന്നും മുന്നറിയിപ്പുണ്ട്.

ഇന്ത്യ മാത്രമല്ല....
കറന്സികളിലെ ബാക്ടീരിയ ഇന്ത്യയില് മാത്രമല്ല പ്രശ്നക്കാരന്. ലോകത്ത് പല രാജ്യങ്ങളിലും ഇത് ഉയര്ന്ന തോതിലാണ് ഉള്ളത്. -96.25 ശതമാനാണ് പലസ്തീന് നോട്ടുകളിലെ കീടാണുക്കളുടെ അളവ്. കൊളംബിയയില് ഇത് 91 ശതമാനമാണ്. ദക്ഷിണാഫ്രിക്കയില് 90 ശതമാനമാണ്. സൗദിയില് ഇത് 88 ശതമാനത്തോളം വരും. മെക്സിക്കോയിലെ പോളിമര് നോട്ടുകളില് ബാക്ടീരിയയുടെ അളവ് 69 ശതമാനമാണ്. ലോകത്തെല്ലായിടത്തും ഇത് ആശങ്കപ്പെടുത്തുന്ന കാര്യം തന്നെയാണ്.

സര്ക്കാരിന് കുലുക്കമില്ല
ഇത്രയും ഗുരുതരമായ കാര്യങ്ങള് നടന്നിട്ടും സര്ക്കാരിന് ഒരു കുലുക്കവുമില്ലെന്ന് അഖിലേന്ത്യ വ്യാപാര സംഘടനയുടെ സെക്രട്ടറി ജനറല് പ്രവീണ് ഖണ്ഡേവാള് പറഞ്ഞു. ആരോഗ്യവകുപ്പ് പൊതുജനതാല്പര്യാര്ത്ഥം ഇക്കാര്യത്തില് എന്തുകൊണ്ട് ഇടപെടുന്നില്ല. സര്ക്കാരിന് വിഷയത്തിന്റെ ഗൗരവം ഇതുവരെ മനസ്സിലായിട്ടില്ലെന്നും അദ്ദേഹം ആരോപിക്കുന്നു. അതേസമയം നോട്ടുകളില് വീണ്ടും പരിശോധന നടത്തേണ്ടി വരും എന്നുള്ളത് കൊണ്ടാണ് സര്ക്കാര് ഇതില് ഇടപെടാതിരിക്കുന്നത്.

ജെയ്റ്റ്ലിക്ക് കത്ത്
ധനമന്ത്രി അരുണ് ജെയ്റ്റ്ലിക്ക് വ്യാപാര സംഘടന ആരോഗ്യ പ്രശ്നങ്ങള് ചൂണ്ടിക്കാട്ടി കത്തയച്ചിട്ടുണ്ട്. ആരോഗ്യ മന്ത്രി ജെപി നഡ്ഡയ്ക്കും ശാസ്ത്ര സാങ്കേതിക വകുപ്പ് മന്ത്രി ഹര്ഷവര്ധനും ഇക്കാര്യത്തില് കത്തയച്ചിട്ടുണ്ട്. കറന്സി നോട്ടുകള് കൂടുതല് ഉപയോഗിക്കുന്നത് വ്യാപാരികളാണെന്നും തങ്ങള് രോഗികളാകുമെന്നും തങ്ങളുടെ ഉപഭോക്താവിനും ഇത് ദോഷം ചെയ്യുമെന്നും സംഘടന പറഞ്ഞു. മെഡിക്കല് കൗണ്സിലും, ഇന്ത്യന് മെഡിക്കല് അസോസിയേഷന് ഇതില് അന്വേഷണം നടത്തണമെന്നും പ്രവീണ് ഖണ്ഡേവാള് ആവശ്യപ്പെട്ടു.












Click it and Unblock the Notifications